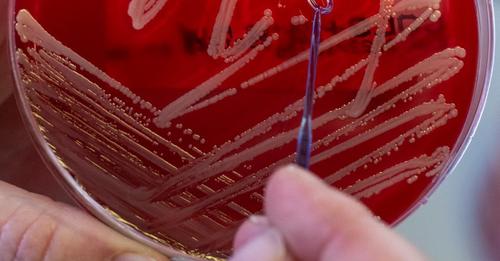

Mutatjuk a várható időjárást!
Két klímaaktivista nő vörös színű levest öntött Leonardo da Vinci világhírű festményére, a Mona Lisárára vasárnap a párizsi Louvre-ban. A „fenntartható élelmiszerhez való jogot” hirdető aktivisták nem tudtak kárt tenni a védőüveg mögött őrzött festményben.
Videón az eset.
/posztok.hu



🤾